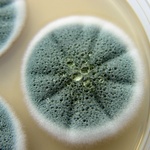

„Mnohé vědecké analýzy nám ukazují, že jednou z příčin vzniku zdravotních problémů je použitý materiál a vlastní provedení stavby. Lze tedy říci, že to, jak svůj dům postavíte a jaké materiály zvolíte, bude v konečném důsledku mít přímý vliv na vaše zdraví,“ říká na úvod náš průvodce zdravým prostředím Tomáš Sysel z Institutu zdravého bydlení, nezávislé platformy, která si dala za cíl zvýšit povědomí o problematice zdraví, staveb a škodlivin v našem prostředí.
Jak rozpoznat škodliviny
Je nepopiratelné, že kořeny toho, jak může budova negativně ovlivnit náš zdravotní stav leží „kdesi pod povrchem“, kde hrají použité materiály důležitou roli a laik nemá vůbec šanci potenciální problém rozpoznat. Navíc každý člověk je jiný a reakce budou zcela jistě rozdílné. Nicméně univerzálně platí to, že jako živočišný druh jsme nejvíce adaptováni na přírodní materiály, které jsou tady s námi po staletí přítomné, což je kámen, dřevo, hlína, sláma, vlna či len. Postupně si zvykáme na celou řadu dalších produktů i na ovzduší s vyšší koncentrací škodlivin.
Červená plíseň Zdroj: Institut zdravého bydlení
„Ovzduší, které dýcháme uvnitř budov, má asi dvakrát až pětkrát větší koncentraci škodlivin než venkovní. Pokud byste ho podrobili laboratorním testům, našli byste jistě prach, viry, bakterie, plísně, roztoče, ale i rozpouštědla nebo těkavé organické sloučeniny. V létě se do tohoto nelahodného koktejlu přidá pyl, v zimě zase smog. Stav venkovního ovzduší hlídá konkrétní zákon o ochraně ovzduší, ale pro to vnitřní, v němž dnes a denně žijeme, žádné závazné normy neexistují. Jeho kvalitu si musíme uvědomit a řešit pouze my sami,“ uvádí Tomáš Sysel a dále seznamuje s nejrůznějšími druhy plísní, které jsou součástí ovzduší i těch, které se nám mohou objevit na stěnách domů a bytů.
Jaké druhy plísní nás ohrožují
Odborníci odhadují, že na světě existuje asi 250 tisíc druhů plísní, z nichž bylo dosud identifikováno pouze 100 tisíc. První věcí, podle níž lze plísně rozpoznat, konstatuje Tomáš Sysel, je jejich barva či množství pigmentovaných výtrusů. „Nicméně konkrétní druh plísní pouze podle barvy přesně určit nelze, druhová identifikace vyžaduje minimálně zhodnocení jejich mikroskopických znaků pomocí laboratorních testů,“ dodává a dále plísně orientačně rozděluje podle barev a ukazuje je na obrázcích.
Kvalita vzduchu v Interiéru Zdroj: Institut zdravého bydlení
Černé plísně
Tyto plísně jsou nejběžnější a také nejobávanější. Nejčastěji je jejich výskyt spojen s vlhkými zdmi. Najdete je na omítnutých stěnách, tapetách nebo spárách mezi dlaždicemi. Navíc to jsou učinění siláci mezi plísněmi, jsou totiž velice odolné. Přežijí ozáření zhruba 200krát větší, než jaké zabije člověka, a ani venkovní teploty pro ně nepředstavují problém – daří se jim při teplotách cca od 6° do 45 °C. Dokonce se objevily i na Mezinárodní vesmírné stanici ISS. Podle konkrétního druhu může být jejich povrch suchý a práškový nebo slizký a šedý. Jedná se o vysoce toxické plísně, mohou vyvolat různá onemocnění, od alergií přes onemocnění ledvin až po závažné infekce.
Bílé plísně
Protože jsou na první pohled poměrně nenápadné, a to zejména na světlých površích, jako jsou omítky, mohou být poměrně dlouho nerozpoznané. Kvůli jejich barvě je obtížné je identifikovat, takže jejich výskyt může indikovat zprvu mírně plesnivý zápach nebo přítomnost roztočů a rybenek. Až po čase zčernají kvůli změně barvy plodného těla. Běžné jsou hlavně v rozích místností, ve výklencích, za nábytkem, na vnějších stěnách nebo v suterénu. Dráždí sliznice a mohou tak vyvolat infekce dutin, časté nachlazení, kožní onemocnění, bolest v krku, kašel, chronickou bronchitidu nebo bolest kloubů. Tyto problémy bývají často nesprávně připisovány suchému vnitřnímu vzduchu. Pokud kvůli tomu začneme pokoj zvlhčovat, jen tím bílé plísni poskytneme lepší podmínky k růstu.
Žlutá pliseň Zdroj: Institut zdravého bydlení
Zelené plísně
Nejčastěji se vyskytují na potravinách, ale mohou se tvořit i na vlhkých stěnách, ve spárách a špatně větraných oblastech, například pod podlahovou krytinou nebo za obklady stěn. Mohou vyvolat alergie, astma, bolesti hlavy, ale hlavně jsou původcem plicní infekce. Zelené plísně se mnohdy objevují společně s jinými druhy plísní, a vytváří tak pestrou směs. V obytných prostorech se nevyskytují často, najdeme je spíše v zemědělských provozech.
Červené plísně
Červené plísně ke svému životu potřebují celulózu, takže se často objevují na papírových tapetách ve vlhkých místnostech. Kromě toho je najdeme i v obilovinách, v mouce, a tedy v pekárnách. Jejich povrch může být jak suchý, tak i slizovitý a může se objevit v různých odstínech červené barvy. Způsobují hlavně onemocnění dýchacího traktu, jako je astma a další.
Žluté plísně
Žluté plísně jsou vysoce nebezpečné, ale v našich zeměpisných podmínkách se díky vysokým hygienickým standardům vyskytují zřídkakdy. Mají méně nápadný vzhled než například černá nebo zelená plíseň. Nejčastěji se objevují ve vlhkých rozích místností, na bavlněných látkách a čalouněném nábytku. Jejich povrch může mít suchou, šupinatou, zrnitou nebo mastnou konzistenci. Žluté plísně uvolňují jed aflatoxin, který má pro člověka karcinogenní účinky, tento druh také může poškozovat dědičnou informaci v buňkách nebo poškodit vyvíjející se plod.

Sdílet / hodnotit tento článek